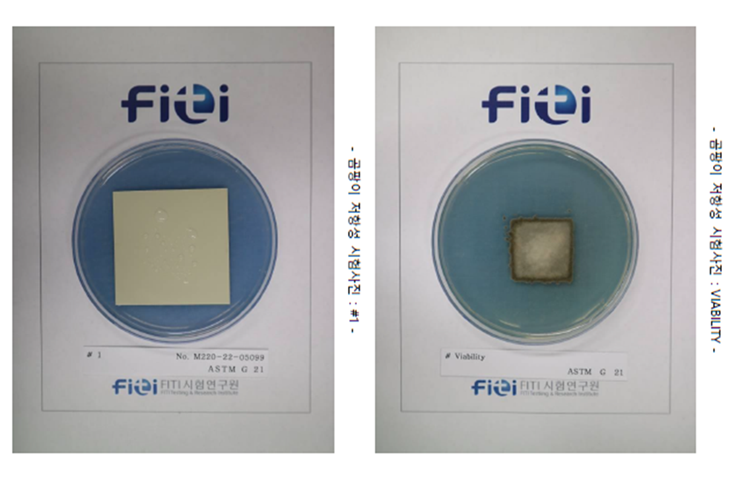

디케이동신(대표 임동규)이 컬러강판의 항곰팡이성을 업계 최초로 인증받았다.
디케이동신은 정부의 ‘건강친화형 주택 건설기준(국토교통부고시 제 2020-368호, 2022.04.30.)‘에 부합하는 항곰팡이 강판을 개발해 종합시험인증기관인 FITI시험연구원(FITI)으로부터 업계 최초로 성능을 인증받았다고 13일 밝혔다. FITI는 한국인정기구(KOLAS)에서 인정한 제1호 국제공인시험기관으로 섬유패션·소비재 산업·환경·바이오 분야를 중심으로 시험, 검사, 인증, 심사와 연구개발 사업 등을 실시하고 있다.
디케이동신에 따르면 내식성을 비롯한 기분 물성과 항균과 항곰팡이 성능을 선전하는 컬러강판은 많았지만 항곰팡이 성능시험에 통과한 것은 디케이동신이 업계 최초다. 그간 여러 업체에서 개발 시도가 이뤄졌으나 기술력의 한계로 인증 기준에 부합해온 것으로 알려졌다.
디케이동신이 개발한 이 항곰팡이 컬러강판은 FITI에서 항곰팡이 저항성(log(CFU)) 테스트를 받았다. 테스트는 ASTM D 6329와 ASTM G-21로 진행된다. 환경으로는 상대습도 85%, 온도 28도에서 28일 배양 후를 평가 기준으로 두고 있으며 ASTM D 6329 시험 규격의 항곰팡이 저항성 1.0log (CFU)이하, ASTM G 21 시험 규격의 0등급 이상 기준을 동시 충족해야 성능을 인증받을 수 있다.
회사는 오염물질 억제 또는 저감 건축자재의 적용 기준 중 항곰팡이 건축자재의 성능평가에 적합한 제품을 만들기 위해 지속 노력해왔다. 그 결과 건축용 실내마감재로 사용하는 제품화된 건축자재인 항곰팡이 강판을 개발했고, 이에 대한 위생성과 안정성을 객관적으로 평가받기 위해 시험을 추진했다.
DK동신 관계자는 “현재는 건축 내외장재용 단색컬러강판에 항곰팡이 성능을 인증 받았고 양산을 위한 준비도 모두 마친 상태다”라며 “향후 프린트강판에 대해서도 성능인증을 진행해 주방용, 인테리어용, 가전제품용 강판 등을 출시할 계획이다”고 말했다.
이어 “신제품 출시로 강판 판매량을 끌어올려 친환경 주택 건설 수요 확보에 적극적으로 나서겠다”며 “공인된 품질력으로 의료시설을 비롯해 고청정을 요하는 무균제약시설, 영유아 교육시설 등에서 항곰팡이 컬러강판의 수요가 창출될 것으로 기대하고 있다”고도 덧붙였다.